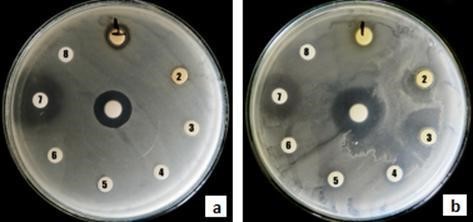
Antimicrobial
activity of extracts obtained from cell suspension cultures of T. peruviana: B. cereus (a) y S. aureus (b).

Artículos
ANTIMICROBIAL ACTIVITY OF CALLUS AND CELL SUSPENSION CULTURES EXTRACTS OF Thevetia peruviana
ACTIVIDAD ANTIMICROBIANA DE CULTIVOS DE CALLOS Y SUSPENSIONES CELULARES DE Thevetia peruviana
ANTIMICROBIAL ACTIVITY OF CALLUS AND CELL SUSPENSION CULTURES EXTRACTS OF Thevetia peruviana
Revista de la Facultad de Ciencias, vol. 8, no. 1, 2019
Universidad Nacional de Colombia
Received: 24 January 2018
Accepted: 15 June 2018
Abstract: Thevetia peruviana is an ornamental plant considered as a source of biological compounds with cardiac and antimicrobial activity. These compounds are normally extracted from different parts of in vivo plants. In this work, extracts were obtained from in vitro callus and plant cell suspension cultures of T. peruviana and their antimicrobial activity was evaluated by disk diffusion tests against gram negative (Salmonella thipimurium and Escherichia coli) and gram positive (Staphylococcus aureus and Bacillus cereus) strains. Ethanol, methanol and hexane extracts from callus and cell suspension cultures showed biological activity. Methanolic cell suspension extract showed activity against B. cereus and S. aureus. Ethanolic cell suspension extract inhibit all the bacteria, especially S. thipimurium while hexanic extract showed resistance activity against S. thipimurium, S. aureus and B. cereus. In terms of the source of the extracts, hexane extracts obtained from cell suspension cultures showed a higher antimicrobial activity than callus, while ethanol extracts had an inverse behavior. These results outline in vitro cell culture of T. peruviana as a feasible biotechnological platform for the production of compounds with antimicrobial activity.
Keywords: Antimicrobial activity, callus culture, plant cell suspension culture, Thevetia peruviana.
Resumen: Thevetia peruviana es una planta ornamental considerada fuente de compuestos biológicos con actividad cardiotónica y antimicrobiana extraídos normalmente de diferentes partes de la planta. En este trabajo se obtuvieron extractos a partir de cultivos de callos y suspensiones celulares de T. peruviana y se evaluó su actividad antimicrobiana mediante pruebas de difusión en disco contra cepas gram negativas (Salmonella thipimurium y Escherichia coli) y gram positivas (Staphylococcus aureus y Bacillus cereus). Los extractos de etanol, metanol y hexano de cultivos de callos y suspensiones celulares mostraron actividad biológica. El extracto de metanol de la suspensión celular mostró actividad contra B. cereus y S. aureus. El extracto etanólico de suspensión celular inhibió todas las bacterias, especialmente S. thipimurium, mientras que el extracto hexanico mostró actividad de resistencia contra S. thipimurium, S. aureus y B. cereus. En cuanto a la fuente de los extractos, los extractos de hexano obtenidos de los cultivos en suspensión celular mostraron una mayor actividad antimicrobiana en comparación con el callo, mientras que los extractos de etanol tuvieron un comportamiento inverso. Estos resultados perfilan el cultivo celular in vitro de T. peruviana como una plataforma biotecnológica factible para la producción de compuestos con actividad antimicrobiana.
Palabras clave: Actividad antimicrobiana, cultivo de callos, cultivo de células en suspensión, Thevetia peruviana.
1. INTRODUCTION
Plants are known for their ability to synthesize a variety of compounds, which have proved to be useful for the treatment of several diseases. It is estimated that approximately two thirds of the active ingredients of anticancer agents and drugs against infectious diseases are derived from plants (McChesney et al., 2007).
Wide variety of metabolites produced by plants are employed by food, chemical, pharmaceutical and cosmetics industries for the production of multiple products and medicines, in a growing market of billions of dollars a year (Sasson et al., 1992).
Within the pharmaceutical industry, antibiotics are the first choice for the treatment of infections. However, continuous and unsupervised uses of currently available antibiotics by the healthcare and agricultural systems have resulted in several bacterial strains (i.e. Bacillus subtilis, Bacillus cereus and Escherichia coli) resistant to these antibiotics. These scenarios make it difficult to implement effective treatments against bacterial infections. In order to overcome this problem, plant extracts with antimicrobial activity, have been used as a complement in order to enhance the activity against resistant bacteria ( Hammer et al., 1999; Rahman et al., 2014). In addition, in recent years, the use of plant extracts with antimicrobial activity which improve the effectiveness of topical creams and lotions has increased significantly (Kareru et al., 2010a). (Error 10: La referencia Hammer et al. debe estar ligada) (Error 11: El tipo de referencia Hammer et al. es un elemento obligatorio) (Error 12: No existe una url relacionada)
Thevetia peruviana (T. peruviana) is a commonly ornamental shrub that belongs to the Apocynaceae family. It is considered a potential source of biological active compounds, exhibiting anti-termite (Kareru et al., 2010b; Tagbor, 2009), antimicrobial (Hassan et al., 2011; Kareru et al., 2010b; Kareru et al., 2010a; Rahman et al., 2014) anti HIV (Tewtrakul et al., 2002) and anticancer (Newman et al., 2008) activities, among others. T. peruviana is particulary know for the production of cardiac glycosides such as thevetin, neriifolin and peruvoside, used as alternative drugs to digoxin in the treatment of heart failure (Zibbu & Batra, 2011).
In the last 15 years, the antimicrobial potential of T. peruviana extracts (leaves, fruits and roots explants) has been intensively studied (Bhoyar & Biradar, 2014; Gezahegn et al., 2015; Reddy, 2010). Reports by several authors have shown promising antimicrobial activity for several extracts, standing out those with presence of phenolic compounds and flavonoids (Cushnie & Lamb, 2005). However, not unanimity as to the solvents used, sensitive bacteria and inhibition halos has arisen from these studies.
Establishment of in vitro cell cultures of T. peruviana could provide a new biotechnological platform for the production of high value compounds with commercial interest (Arias et al., 2010), including antimicrobial agents. Few studies have evaluated the antimicrobial activity of in vitro cell cultures of T. peruviana (Alhashimi et al., 2013). However, to the best of our knowledge, there has not been published any work which compare and correlated callus and cell suspension cultures with the antimicrobial activity. Therefore, this work aims to evaluate the antimicrobial potential of different extracts from callus and cell suspension cultured of T. peruviana.
2. MATERIALS AND METHODS
2.1. Plant material, callus and cell suspension cultures
Fresh biomass obtained from friable callus and cell suspensions were freezed/dried (SYCLON-18N) at 60◦C and 1 bar during 48 hours to avoid degradation of thermolabile compounds.
Callus and cell suspension cultures were obtained following the protocol described by (Arias et al., 2010). Fruits were disinfected through washes with ethanol (70% v/v), sodium hypochlorite (10% w/v) and sterile distilled water. Aseptic pulp explants were sowed in solid Schenk and Hildebrandt (SH) medium supplemented with sucrose (30 g/L), 2.4-D (2 mg/1), kinetin (0.5 mg/L) and agar-agar (7 g/L). Explants were subcultured every 15 days in fresh medium until friable callus were obtained.
Cell suspension cultures were obtained through transfer of 2 g of friable callus to 100 mL of liquid SH medium in a 250 mL flask. Cell suspensions were maintained under constant agitation (110 rpm), 25±3◦C and natural photoperiod (12h day light/12h darkness). Suspension cell cultures were subcultured every 12-15 days.
Fresh biomass obtained from friable callus and cell suspensions were freezed/dried (SYCLON-18N) at 60◦C and 1 bar during 48 hours to avoid degradation of thermolabile compounds.
2.2. Phytochemical analysis
Preliminary phytochemical analysis was conducted according to some modifications to the standard protocol described by Harborne (1873). 2 g of freezed/dried biomass from callus and cell suspension cultures were extracted with 50 mL of solvent, then each extract was concentrated to a volume of 2 mL in a rotary evaporator (IKA HB10 control) at 40◦C, 110 rpm and 145 psi. Each extract was used according to the methodology described for each family of metabolites to be identified according to Harborne (1973) for Thin Layer Chromatography (TLC) determination. Compounds families and tests performed are shown in Table 1. Results are reported on a qualitative scale as negative or positive: low (+), medium (++), or high (+++).
| Metabolite | Test |
| Alkaloids | Dragendorff Mayer Valser |
| Steroids | Lieberman-Bourchard |
| Flavonoids | Shinoda |
| Phenols and tannins | FeCl3 and Jelly |
| Saponins | Foam |
| Anthroquinones | Brötager |
| Sesquiterpenic lactones | Baljet Kedde Legal |
| Cardiac glycosides | Kedde Legal |
2.3. Callus and cell suspension culture extracts preparation
In order to make an exploratory study of various crude extracts eight solvents of different polarities were used for extractions; in ascending polarity (methanol, ethanol, acetone, ethyl acetate, dichloromethane, chloroform, hexane and petroleum ether). About 1.5 g of freezed/dried biomass (callus and cell suspensions) was used, for each extract, in a Soxhlet apparatus with 100 mL of solvent during five siphon cycles. Solvents were evaporate in their entirety under reduce pressure (145 psi) using a rotary evaporator system (IKA RV 10 control) at 40◦C using a water bath (IKA HB 10 control). Each extract was diluted in 1 ml of dimethylsulfoxide (DMSO) 6% v/v, obtaining the maximum extract concentration to be evaluated. All the extracts were stored at 4◦C in the dark until use.
2.4. Bacterial strains and cultures
Tested bacterial included two gram-negative strains: Salmonella thipimurium (S. thipimurium) (ATCC 14028), Escherichia coli (E. coli) (ATCC 8739) and two gram-positive strains: Staphylococcus aureus (S. aureus) (ATCC 49775), Bacillus cereus (B. cereus) (ATCC 10987). The main characteristics of the bacteria strains are described in Table 2.
Each strain was activated on nutrient agar 24 hours before susceptibility testing. Bacterial solution was prepared by transferring a loop-full of three colonies of each bacteria into test tubes containing 5 mL of saline solution (0.8% weight/volume of sodium chloride). The bacterial concentration were adjusted to 0.5 McFarland standard (absorbance 0.08-0.13 at 625 nm) (Sutton, 2011).
| Bacteria | Gram reaction | Shape | Aerobic growth | Anaerobic growth | Endospore formation |
| S. thipimurium | - | Rods | + | - | - |
| E. coli | - | Rods | + | - | - |
| S. aureus | + | Cocci | + | + | - |
| B. cereus | + | Rods | + | - | + |
Antibacterial activity assay was tested by agar diffusion test (Bauer et al., 1966). A sterile swab, impregnated with the prepared bacterial solution was used to surface inoculate a petri dish with Mueller Hilton agar in order to obtain a homogeneous bacteria growth. 20 µL of each extracts were deposited in 6 mm diameter sterile discs (MN 827 ATD) which were placed on the surface of each inoculated petri dish. Petri dishes were stored at 4◦C for 2 hours to allow the diffusion in the agar of the extracts before bacterial growth. Next, petri dishes were incubated at 36◦C, between 24 and 30 hours. All organic solvents and DMSO were evaluated as the negative control and tetracycline at a concentration of 2 mg/disc was used as positive control. All the assays were performed in duplicate. Inhibition values were reported as the average total diameter (diameter disc + inhibition).
3. RESULTS AND DISCUSSION
3.1. Phytochemical analysis
Phytochemical analysis of callus and plant cell suspension cultures obtained by TLC is shown in Table 3. Both in vitro culture systems showed the presence of cardiac glycosides and flavonoids. In addition, cell suspensions showed the presence of phenolic compounds.
These results are consistent with those reported by previous research. Presence of cardiac glycosides in extracts of different parts of the in vivo plant (Gezahegn et al., 2015; Kohls et al., 2012; Mateus, 2012) as well as in vitro callus and suspension cultures (Alhashimi et al., 2013; Arias et al., 2010) had been reported. Other authors have detected presence of more families of secondary metabolites such as alkaloids, terpenoids, saponins, flavonoids and phenols (Arias et al., 2016; Bhoyar & Biradar, 2014; Gezahegn et al., 2015).
Differences in types of metabolites with other authors and among themselves may lie in the source of the plant used to obtain the extracts as well as the different growing conditions of the same.
| Metabolite | Callus | Cell suspension |
| Alkaloids | Negative | Negative |
| Steroids | Negative | Negative |
| Flavonoids | Positive + | Positive + |
| Phenols and tannins | Negative | Positive + |
| Saponins | Negative | Negative |
| Anthraquinones | Negative | Negative |
| Sesquiterpenic lactones | Negative | Negative |
| Cardiac glycosides | Positive + | Positive ++ |
3.2. Antibacterial activity of cell suspension cultures
Table 4 shows the final concentration for each extracts; note that the concentration of the extract decreases with decrease of solvent polarity.
| Solvent | Extract Concentration (mg/ml) |
| Methanol | 475.6 |
| Ethanol | 454.5 |
| Acetone | 122.9 |
| Ethyl Acetate | 55.2 |
| Dichloromethane | 56 |
| Chloroform | 47.7 |
| Hexane | 59.7 |
| Petroleum Ether | 39.8 |
Methanol, ethanol and hexane extracts showed the best antibacterial activity. Representative results for B. cereus and S. aureus are shown in Figure 1.
The total diameter of inhibition presented by the extracts in all bacterial strains is shown in Table 5.
Methanol extracts showed activity against B. cereus and S. aureus with inhibition diameters of 11 and 9 mm, respectively (Table 5). Ethanol extract showed greatest inhibition against S. thipimurium (inhibition diameter of 14 mm) while for the remaining strains the inhibition diameters were of 9 mm. Hexane extract showed a resistance diameter of 23 mm for S. thipimurium and inhibition diameters of 17 and 19.3 mm for
(1: methanol, 2: ethanol, 3: acetone, 4: ethyl acetate, 5: dichloromethane, 6: chloroform, 7: hexane, 8: petroleum ether, center: tetracycline).
Own elaboration.S. aureus and B. cereus, respectively. In contrast, hexane did not show activity against E. coli. None of the others extracts showed antibacterial activity against more than one strain, as in the case of Ethyl Acetate who only presented an inhibition diameter of 11 mm against S. aureus.
| Solvent | Concentration (mg/disc) | Total diameter inhibition zone (mm) | |||
| E. coli | S. thipimurium | B. cereus | S. aureus | ||
| M | 9.5 | - | - | 11 | 9 |
| E | 1.5 | 9.7 | 14 | 9 | 9 |
| A | 2.5 | - | - | - | - |
| EA | 1.1 | - | - | - | 11 |
| D | 1.1 | - | - | - | - |
| C | 1 | - | - | - | - |
| H | 1.2 | - | 23* | 19.3 | 17 |
| PE | 0.8 | - | - | - | - |
| Tetracycline | 2 | 17.3 | 18 | 16 | 19 |
(M: Methanol, E: Ethanol, A: Acetone, EA: Ethyl Acetate, D: Dichloromethane, C: Chloroform, H: Hexane, PE: Petroleum Ether).
Gezahegn et al. (2015) observed increased antibacterial activity for ether extract from leaves of T. peruviana against E. coli (13.50 mm) and S. typhimurium (16.50 mm), while the acetone extract was more effective against S. aureus (17.00 mm). Naz and Agrawal, working with ethanol extracts of leaves of T. peuruviana observed a concentration depend antibacterial activity for E. coli and S. aureus (Naz & Agrawal, 2015). Rahman et al. (2014) reported for ethanol extracts of leaves and fruits (1.5 mg/well), maximum inhibition diameters for E. coli of 10.33 and 9.33 mm, respectively. Alhashimi et al. (2013), compared the activity of alcohol extracts of leaves and callus of T. peruviana, seeing increased antibacterial activity in callus extracts against S. aureus (15 mm) and P. aeruginosa (13 mm) for the extracts of 40 mg/well and B. cereus (12 mm) to concentration of 35 mg/well. Both extracts showed resistance to E. coli. Moreover, Hassan et al. (2011), reported very low inhibition values for ethanol extracts of leaves at concentrations of 100 µg/disc on gram positive and gram negative bacteria, particularly S. sonnei (1.5 mm), S. aureus (2.7mm ) and B. cereus (0 mm).
Other authors have reported antimicrobial activity of extracts obtained from leaves of Thevetia neriifolia, obtaining very good results against human pathogens (bacteria and fungi) for aqueous and hexane extracts (Buvaneswari et al., 2011), ethanol, ethyl acetate, chloroform and methanol (Buvaneswari et al., 2011; Nesy & Mathew, 2014).
Methanol, ethanol and hexane extracts showed a greater inhibitory effect on the inhibition growth of grampositive bacteria than for gram-negative bacteria, which is in accordance with the reports described above.
The results obtained in this work for ethanol and hexane extracts are very similar to those reported by some of the previously mentioned authors. They have mainly worked with extracts obtained from fruits and leaves, indicating that the in vitro culture of cell suspensions of T. peruviana is a feasible strategy for the production of compounds with antimicrobial activity of alternative species. Because of this, it was evaluate the differential antibacterial activity that could occur in two different systems of in vitro plant cell cultures, callus and suspensions.
3.3. Effect of the in vitro culture (callus or suspensions) on the antibacterial activity of ethanol and hexane extracts
Callus and suspension hexane extracts (Table 6) did not show activity against E. coli, corroborating the results obtained in the sweep solvent made for cell suspensions (Table 5). Hexane extracts showed the same activity against B. cereus and S. aureus; in the case of S. thipimurium showed a higher antibacterial activity changing to a clear inhibition zone instead of a resistance halo; this change may be due to increased concentration tested, from 1.5 to 2 mg of extract per disc.
Suspension hexane extracts showed a slightly higher antibacterial activity than the obtained for callus against all tested bacteria strains. Moreover, callus ethanol extracts showed antibacterial activity slightly higher than that obtained for cell suspensions, except for B. cereus, which did not register any callus activity and very low activity for the suspensions (8 mm).
Callus antimicrobial activity observed in this study is higher compared to Alhashimi et al. (2013), who reached similar inhibition ranges but whit higher concentration of the extracts. The observed difference in activity may be due either to the source of explant used to obtain callus, Alhashimi et al. (2013) employed leaves instead of pulp fruit. In addition, the age of the culture used to obtain extracts as well as specific endemic characteristics of the used plants can contribute to the observed differences.
| material | mg/disc | E. coli | S. thipimurium | B. cereus | S. aureus | |
| Suspension | E | 1.6 | 9.7 | 14.0 | 8.0 | 13.3 |
| Callus | 1.4 | 14.7 | 16.7 | - | 15.0 | |
| Suspension | H | 2.0 | - | 14.7 | 13.3 | 14.0 |
| Callus | 1.9 | - | 11.0 | 10.7 | 12.0 | |
| Antibiotic Tetracycline | 2 | 15.7 | 16.0 | 16.3 | 16.3 |
Differences in antimicrobial activity between callus and cell suspensions extracts can be considered as evidence of the effect on the production of active compounds in two different culture systems (solid for callus and liquid for suspensions). This effect has been demonstrated in the case of T. peruviana by Alhashimi et al. (2013) who observed increased activity in alcoholic extracts obtained from in vitro cell callus compared to extracts of in vivo leaves.
Although a difference was observed in the antibacterial activity of the extracts obtained from callus and cell suspensions, it is quite complex to attribute this activity only to the difference observed in the phytochemical profile. TLC is a preliminary technique and does not allow to identify accurately neither the type of compounds nor the concentration of each of the families that were identified.
These results are encouraging to continue in the subsequent fragmentation of the extracts that showed to have biological activity. Identify the active compound, determine the IC50, purify it and eventually establish its biotechnological production on a larger scale.
4. CONCLUSIONS
he results of this study indicate that ethanol and hexane extracts obtained from in vitro cultures of T. peruviana (callus and suspensions) present antibacterial activity in the tested strains. Antibacterial activity was higher against gram-positive bacteria (S. aureus and B. cereus). In vitro cultures of T. peruviana showed similar antibacterial activity to those reported by other authors in previous works for in vivo plant extracts. These results establish this in vitro culture as a promising biotechnological platform for obtaining natural compounds with antimicrobial activity having the advantages of in vitro cultivation above in vivo cultures.
5. ACKNOWLEDGEMENTS
The authors are grateful to the Facultad de Ciencias of Universidad Nacional de Colombia, Medellin, for the support to carry out this work, and Colciencias for providing a grant to Juan Pablo Arias.
References
Alhashimi, S. K.; Rashid, K. I.; Saleh, G. S.; Abdulhadi, A. M. & Taher, T. A. (2013). The antimicrobial activity of leaves and callus extracts of Thevetia peruviana in vitro. Jornal of Biotechnology Research Center, 7(3), 74–80.
Arias, J. P.; Zapata, K.; Rojano, B. & Arias, M. (2016). Effect of light wavelength on cell growth, content of phenolic compounds and antioxidant activity in cell suspension cultures of Thevetia peruviana. Journal of Photochemistry and Photobiology B: Biology, 163, 87–91.
Arias, M.; Angarita, M.; Restrepo, J. M.; Caicedo, L. A. & Perea, M. (2010). Elicitation with methyljasmonate stimulates peruvoside production in cell suspension cultures of Thevetia peruviana. In Vitro Cellular & Developmental Biology-Plant, 46(3), 233–238.
Bauer, A. W.; Kirby, W. M. M.; Sherris, J. C. & Turck, M. (1966). Antibiotic susceptibility testing by a standardized single disk method. American Journal of Clinical pPathology, 45(4_ts), 493–496.
Bhoyar, S. & Biradar, S. (2014). Antibacterial activity of root extract of Thevetia peruviana (Pers.) Shum. International Research Journal of Pharmacy, 5(6), 468–470.
Buvaneswari, K.; Ramamoorthy, D. & Velanganni, J. (2011). Preliminary phytochemical and antimicrobial activity studies on the leaves of the Indian plant Thevetia neriifolia JUSS. World Journal of Agricultural Sciences, 7(6), 659–666.
Cushnie, T. P. T. & Lamb, A. J. (2005). Antimicrobial activity of flavonoids. International Journal of Antimicrobial Agents, 26, 34–356
Gezahegn, Z.; Akhtar, M. S.; Woyessa, D. & Tariku, Y. (2015). Antibacterial potential of Thevetia peruviana leaf extracts against food associated bacterial pathogens. Journal of Coastal Life Medicine, 3(2), 150– 157.
Hammer, K. A.; Carson, C. F. & Riley, T. V. (1999). Antimicrobial activity of essential oils and other plant extracts. Journal of Applied Microbiology, 86(6), 985–990.
Hassan, M. M.; Saha, A. K.; Khan, S. A.; Islam, A.; Mahabub-Uz-Zaman, M. & Ahmed, S. S. U. (2011). Studies on the antidiarrhoeal, antimicrobial and cytotoxic activities of ethanol-extracted leaves of yellow oleander (Thevetia peruviana). Open Veterinary Journal, 1(1), 28–31.
Harborne, J. B. (1973) Phytochemical Methods. A guide to modern techniques of plant analysis. London:
Kareru, P. G.; Keriko, J. M.; Kenji, G. M.; Thiong’o, G. T.; Gachanja, A. N. & Mukiira, H. N. (2010a). Antimicrobial activities of skincare preparations from plant extracts. African Journal of Traditional, Complementary and Alternative Medicines, 7(3), 214–218.
Kareru, P. G.; Keriko, J. M.; Kenji, G. M. & Gachanja, A. N. (2010b). Anti-termite and antimicrobial properties of paint made from Thevetia peruviana (Pers.) Schum. oil extract. African Journal of Pharmacy and Pharmacology, 4(2), 87–89.
Kohls, S.; Scholz-Böttcher, B. M.; Teske, J.; Zark, P. & Rullkötter, J. (2012). Cardiac glycosides from Yellow Oleander (Thevetia peruviana) seeds. Phytochemistry, 75, 114–127.
Mathuravalli, K. & Lakshmi, R. E. (2012). Analysis of phytochemical components and anti-microbial activity of the toxic plant-Thevetia Peruviana. Indian Journal of Innovations and Developments, 1(2), 97–101.
McChesney, J. D.; Venkataraman, S. K. & Henri, J. T. (2007). Plant natural products: back to the future or into extinction? Phytochemistry, 68(14), 2015–2022.
Naz, S. & Agrawal, S. (2015). Evaluation of antimicrobial activity of ethanolic extract of Thevetia peruviana (kaner) leaves. Indian Journal of Life Sciences, 5(1), 17–20
Nesy, E. A. & Mathew, L. (2014). Studies on antimicrobial and antioxidant efficacy of Thevetia neriifolia, Juss leaf extracts against human skin pathogens. International Journal of Pharmaceutical Sciences and Drug Research, 6(2), 164–168.
Newman, R. A.; Yang, P.; Pawlus, A. D. & Block, K. I. (2008). Cardiac glycosides as novel cancer therapeutic agents. Molecular interventions, 8(1), 36–49
Rahman, N.; Mahmood, R.; Rahman, H. & Haris, M. (2014). Spectrophotometric screening of potent bactericidal property of Thevetia peruviana Schum. leaf and fruit rind extracts on clinical and plant pathogens. International Journal of Applied Sciences and Biotechnology, 2(4), 451–459.
Reddy, B. U. (2010). Antimicrobial activity of Thevetia peruviana (Pers.) K. Schum. and Nerium indicum Linn. Internet Journal of Pharmacology, 8(2), 2.
Sasson, A.; Silva, E. & Ratledge, C. (1992). Production of useful biochemicals by higher-plant cell cultures: biotechnological and economic aspects. Biotechnology-Economic and Social Aspects: Issues for Developing Countries, 81–109.
Sutton S. (2011). Growth measurement. Determination of Inoculum for Microbiological Testing. Journal of GXP Compliance, 15(3), 49–53.
Tagbor, T. A. (2009). The anti-termite properties and basic phytochemicals of eight local plants and the chemical characterisation of thevetia peruviana (pers) k. schum in Ghana (Doctoral dissertation).
Tewtrakul, S.; Nakamura, N.; Hattori, M.; Fujiwara, T. & Supavita, T. (2002). Flavanone and flavonol glycosides from the leaves of Thevetia peruviana and their HIV-1 reverse transcriptase and HIV-1 integrase inhibitory activities. Chemical and Pharmaceutical Bulletin, 50(5), 630–635.
Zibbu, G. & Batra, A. (2011). Thevetia peruviana (Pers.) Schum.: A plant with enormous therapeutic potential. Journal of Pharmacy Research, 4(12), 4461–4464.
Additional information
Autores: Arias, J. P.; Ortega, I.; Peñuela, M. & Arias, M.
(2018). Antimicrobial activity of callus and
cell suspension cultures extracts of Thevetia peruviana. Rev. Fac.
Cienc., 8(1), 45–56. DOI: https://doi.org/10.15446/rev.fac.cienc.v8n1.69976 / Grupo de Biotecnología Industrial, Facultad de
Ciencias, Universidad Nacional de Colombia sede Medellín. jpariase@unal.edu.co / Grupo
de Biotecnología Industrial, Facultad de Ciencias, Universidad Nacional de
Colombia sede Medellín. icortegab@unal.edu.co / Grupo de Bioprocesos, Facultad de Ingeniería, Universidad
de Antioquia. mariana.penuela@udea.edu.co / Grupo de Biotecnología Industrial, Facultad de
Ciencias, Universidad Nacional de Colombia sede Medellín. marioari@unal.edu.co

